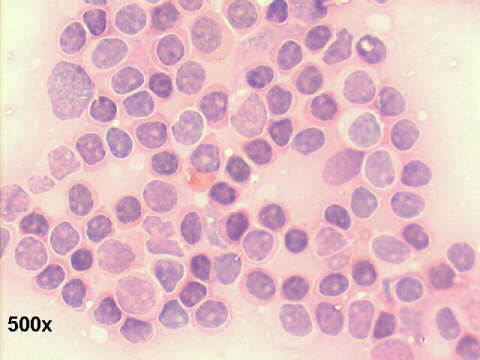
500x Papanicolaou staining

Drs. Prolla and Diehl's
INTERESTING CASE OF THE MONTH October 2003 case A
FNA inguinal node, 69-year old male with Left testicle enlargement, and left inguinal node

Case
of the month answer
Click here for case B

 or case C
or case C

Best seen on 1024x768x16M resolution -

or case C
or case C
